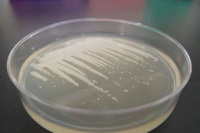
寒天培地上でコロニーを形成するプロトテカ（Prototheca cutis JCM 15793）。（画像：筑波大学発表資料より）

筑波大学芸術系の佐伯いく代准教授、生命環境系の平尾章助教、田中健太准教授、および北海道大学北方生物圏フィールド科学センターの日浦勉教授らの研究グループは、カエデの一種であり絶滅危惧種であるクロビイタヤについて、森が分断された際にその生存状況がどう変にしていくのかを調査した。
03/05 21:59
慶應義塾大学先端生命科学研究所(山形県鶴岡市、冨田勝所長)の荒川和晴准教授(環境情報学部)、ポーランド・ヤギェウォ大Lukasz Michalczyk准教授らの共同研究グループは、山形県鶴岡市内で新種のクマムシを発見、これを「ショウナイチョウメイムシ」(ラテン名:Macrobiotus shonaicus)と命名した。
03/05 16:00
京都大学の潮雅之 生態学研究センター研究員、 益田玲爾 フィールド科学教育研究センター准教授、近藤倫生 龍谷大学教授らが参加した日本・台湾・アメリカの学者たちからなる国際研究グループが、京都府北部舞鶴湾における12年間におよる調査の結果として、生態系を構成するそれぞれの種の数的バランスは複雑な種間の関係性によって維持されていることを明らかにした。
02/15 21:28
京都大学などの研究グループは、アンフランジと呼ばれる劣位の個体であっても、オランウータンは子孫を残せると言う研究結果を発表した。
02/07 07:52
北海道大学を中心とし、名古屋大学も参加している共同研究グループが、グリーンランドで氷の採掘を行い、その科学的分析から、過去60年分の北極大気環境を割り出した。
01/31 16:36
産業技術総合研究所(産総研)の研究グループは、害虫の殺虫剤抵抗性が、共生細菌を介することによって従来考えられていたよりも遥かに急速に出現・進化することを明らかにした。
01/24 11:50
プロトテカという緑藻がいる。緑藻なのだが、色は白い。つまり、広義の分類学上の位置付けで緑色植物門(緑藻)に含まれるのだが、葉緑素を持たず、光合成も行わず、色が白いのである。
01/22 07:00
約50年前に侵略的外来種として小笠原諸島・父島に入り込んだトカゲの一種グリーンアノールが、その50年の間に急速な適応進化を遂げていたその実態が、東北大学の研究により明らかにされた。
12/26 15:05
静岡県焼津市の市役所水産部ふるさと納税課が、一定額のふるさと納税納税者に対して、ペット用の、つまり生きたままの、オオグソクムシのお礼品申し込みをスタートさせた。
12/23 20:15
米アラスカで今までに無いような気候変動が発生したため、気候観測システムがデータを異常とみなして処理を行わないという事態が発生していたそうだ(GIGAZINE、New Tork Times、Washington Post)。
12/17 19:00
元広島大学の澤井悦郎博士のチームがフグ目マンボウ科マンボウ属の分類をめぐる混乱を解決し、今まで捕獲された魚類の中で「最も重い硬骨魚」はウシマンボウだったことを論文発表した。
12/12 10:54
サクラマスとその寄生者であるカワシンジュガイの関係において、サクラマスの合理的な行動が、カワシンジュガイを利する結果に繋がる、ということを北海道大学が明らかにした。
11/20 06:22
京都大学、岡山大学、琉球大学などの研究グループが、日本の在来種のアリであるオオハリアリが、アメリカにおいて同地の在来種を駆逐、外来種として分布を拡大していることを明らかにした。
11/18 21:58
トランプ大統領は地球温暖化について懐疑的で、地球温暖化は中国のでっち上げなどと主張しているが、米政府が11月3日、気候変動は人間の活動によって引き起こされている可能性が極めて高いという特別報告書を公表した(AFP)。
11/08 10:04